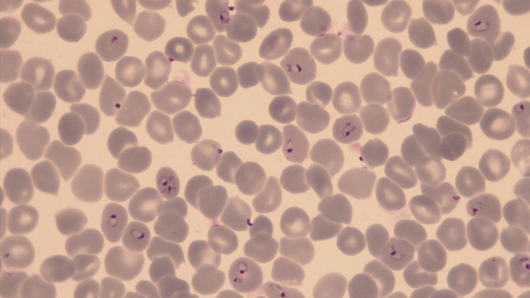
Red blood cells infected with P. falciparum (Photo: A. Passecker, Swiss TPH)

| |
|
Open in browser
|
| |
|
|
|
| |
|
Swiss TPH News, October 2025
|
| |
|
|
|
| |
|
Advancing Next-Generation Malaria Vaccines
|
| |
|
A clinical trial in Tanzania by the Ifakara Health Institute and Swiss TPH found the SUM-101 malaria vaccine to be safe and to trigger strong immune responses in adults exposed to malaria. As currently approved vaccines fall short of the 90%+ efficacy required for eradication, SUM-101, developed by Sumaya Biotech, represents a promising step towards achieving higher and longer-lasting protection against malaria.
|
| |
|
|
| |
|
|
|
|
| |
|
New Drug Candidate to Tackle Resistant Malaria Strains
|
| |
|
Resistance is rising not only in bacteria but also in malaria parasites. As existing medicines lose effectiveness, researchers from Swiss TPH, HIPS and partners have developed a new drug candidate that can kill malaria parasites even when standard treatments fail. Read more
|
|

|
| |
|
From Research to Impact: Addressing FGS
|
| |
|
Female Genital Schistosomiasis (FGS) affects around 50 million women and girls. Despite its devastating impact, FGS remains largely absent from global health agendas. WINGS-4-FGS aims to improve care and raise awareness of this neglected disease. Read more
|
|
|
|
|

|
| |
|
Thirty Years of Research Partnership with Chad
|
| |
|
The first Scientific Days at the new Public Health Institute (INSAPT) in Chad celebrated thirty years of partnership between Swiss TPH and Chadian institutions, and showcased joint research initiatives on diseases, digital health and sustainable health systems. Read more
|
|

|
| |
|
Improving Healthcare for People with Chronic Diseases
|
| |
|
Swiss TPH hosted a symposium on Integrated People-Centred Care, bringing together experts from health, social care, research, and policy. A white paper captures key insights and recommendations to advance integrated care for chronic diseases. Read more
|
|
|
|
|
|
|
|
Reducing Chronic Disease Gaps in West Africa
|
| |
|
The EMPOWER project aims to reduce the burden of chronic diseases in Benin and Togo by training health workers and using digital tools to close treatment gaps. Read more
|
|
|
|
|
|
|
|
Adapting Malaria Strategies to Local Realities
|
| |
|
Swiss TPH experts contributed to a WHO manual guiding countries in tailoring malaria interventions to local contexts for greater impact and efficiency. Read more
|
|
|
|
|
|
|
|
An Interdisciplinary Look at Canine Disease Transmission
|
| |
|
The Tracking Tails project explores how dog movements and human behaviour shape disease spread to design effective, culturally adapted control strategies. Read more
|
|
|
|
|
|
|
|
Universal Health Insurance in Tanzania
|
| |
|
Swiss TPH is supporting Tanzania in strengthening public health insurance management, expand coverage, and build institutional and regulatory capacity. Read more
|
|
|
|
|
|
Swiss TPH Welcomes High Number of New Students
|
| |
|
Over 90 new master’s and PhD students from more than 30 countries have joined Swiss TPH this autumn. The record enrolment in MSc programmes reflects growing interest in Swiss TPH’s educational programmes, which equips future health leaders to address global challenges. Read more
|
|
|
|
|
|
|
Read from Our Alumni
|
| |
|
Cristin Connor talks about how the MBA in International Health Management at Swiss TPH sharpened her ability to see health through a global lens. Read more
|
|
|
|
|
We are pleased to announce the Swiss TPH Symposia 2026:
4 June 2026: The Sleeping Beast: Dealing with Dormant Stages to Tackle Infectious Diseases
9 September 2026: From Knowledge to Impact: Transformational Learning in Global Health
Check our website for updates.
|
|
|
|

|
| |
|
Congratulations
|
| |
|
Aita Signorell received the Venia docendi for Epidemiology from the University of Basel. Read more
|
|
|
|
Sabin Nsanzimana, Minister of Health of Rwanda and Swiss TPH alumnus, was named a TIME100 Next 2025 Innovator. Read more
|
|
|
|
Stefanie Knopp and Marloes Eeftens have been appointed Adjunct Professor for Epidemiology at the University of Basel. Read more
|
|
|
|
|
•
|
Rojas VMR, Zwyer M, Bouaouina S, et al. Mycobacterium tuberculosis complex Lineage 1: A neglected cause of tuberculosis. PLoS Neglected Tropical Diseases. Read full article
|
|
|
|
|
•
|
Fakih BS, Seidahmed O, Holzschuh A, et al. Determinants of locally acquired malaria infections in Zanzibar: a cross-sectional study. Malaria Journal. Read full article
|
|
|
|
|